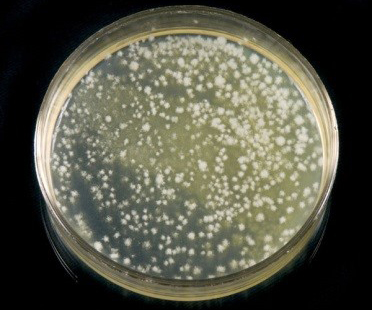

HiMedia: диски с антибиотиками, среды, агары, бульоны, добавки
10.08.2019
Компания HiMedia, основанная в 1975 году, является одним из лидеров по ассортименту поставляемых питательных сред для бактериологии и вирусологии. Продукция HiMedia насчитывает несколько тысяч наименований и соответствует требованиям Фармакопеи США, Европейской Фармакопеи и Британской Фармакопеи. Диски для определения чувствительности к антибиотикам на плотном агаре в чашках Петри
Рекомендации по применению дисков: для правильной интерпретации результатов при определении антибиотикочувствительности следует применять агар Мюллера-Хинтона или агар Мюллера-Хинтона №2, а для грибов – агар Мюллера-Хинтона (модифицированный, для определения чувствительности к антимикотикам, по стандарту CLSI). Диски могут использоваться совместно с диспенсором для равномерного нанесения дисков с антибиотиком на поверхность агара.
 |

|
 |

|

|
Пока нет данных. Перейти в каталог
|
SD110-5VL
|
|
500 шт/уп
|
12 759
12 759 AMD
|
|
|
||||||
|
SD252-5VL
|
|
500 шт/уп
|
хранение -20°C
|
18 319
18 319 AMD
|
|
|
|||||
|
SD072-5VL
|
|
500 шт/уп
|
12 759
12 759 AMD
|
|
|
||||||
|
SD266-5VL
|
|
500 шт/уп
|
18 319
18 319 AMD
|
|
|
||||||
|
SD253-5VL
|
|
500 шт/уп
|
хранение -20°C
|
18 319
18 319 AMD
|
|
|
|||||
|
SD203-5VL
|
|
500 шт/уп
|
хранение -20°C
|
18 319
18 319 AMD
|
|
|
|||||
|
SD048-5VL
|
|
500 шт/уп
|
транспортировка -20°C
|
12 759
12 759 AMD
|
|
|
|||||
|
SD157-5VL
|
|
500 шт/уп
|
12 759
12 759 AMD
|
|
|
||||||
|
SD047-5VL
|
|
500 шт/уп
|
хранение -20°C
|
12 759
12 759 AMD
|
|
|
|||||
|
SD043-5VL
|
|
500 шт/уп
|
транспортировка -20°C
|
16 109
16 109 AMD
|
|
|
|||||
|
Антибиотический препарат группы пенициллинов.
|
|||||||||||
|
SD028-5VLисг
|
|
500 шт/уп
|
транспортировка -20°C
|
По запросу По запросу |
|
|
|||||
|
SD112-5VL
|
|
500 шт/уп
|
транспортировка -20°C
|
15 397
15 397 AMD
|
|
|
|||||
|
SD002-5VL
|
|
500 шт/уп
|
транспортировка -20°C
|
12 759
12 759 AMD
|
|
|
|||||
|
SD264-5VL
|
|
500 шт/уп
|
транспортировка -20°C
|
15 397
15 397 AMD
|
|
|
|||||
|
SD076-5VL
|
|
500 шт/уп
|
транспортировка -20°C
|
12 759
12 759 AMD
|
|
|
|||||
|
SD063-5VL
|
|
500 шт/уп
|
17 250
17 250 AMD
|
|
|
||||||
|
|
|||||||||||
Популярные питательные среды и компоненты
 |

|
|
Пока нет данных. Перейти в каталог
|
SL001-10SL
|
|
10 флаконов
|
Регистрационное удостоверение на медицинское изделие
Росздравнадзора
|
24 093
24 093 AMD
|
|
|
|||||
|
Для культивирования микобактерий, в частности M.tuberculosis.
|
|||||||||||
|
M543-100G
|
|
100 г
|
Регистрационное удостоверение на медицинское изделие
Росздравнадзора
|
82 115
82 115 AMD
|
|
|
|||||
|
Для микробиологического исследования по определению фолиевой кислоты в сыворотке крови с использованием в качестве тест-микроорганизма штамма Lactobacillus casei ATCC 7469.
|
|||||||||||
|
HiMedia
|
|||||||||||
|
M063-500G
|
|
500 г
|
По запросу По запросу |
|
|
||||||
|
Используют для культивирования кислотолюбивых бактерий.
|
|||||||||||
|
HiMedia
|
|||||||||||
|
M002-500G
|
|
500 г
|
41 699
41 699 AMD
|
|
|
||||||
|
Используют в качестве основной среды для культивирования не очень прихотливых микроорганизмов.
|
|||||||||||
|
HiMedia
|
|||||||||||
|
M1145-500G
|
|
500 г
|
Регистрационное удостоверение на медицинское изделие
Росздравнадзора
|
93 733
93 733 AMD
|
|
|
|||||
|
Для селективного выделения видов Listeria.
|
|||||||||||
|
M843-500G
|
|
500 г
|
Регистрационное удостоверение на медицинское изделие
Росздравнадзора
|
82 329
82 329 AMD
|
|
|
|||||
|
Для селективного выделения из клинического материала и пищевых продуктов.
|
|||||||||||
|
M1282-500G
|
|
500 г
|
Регистрационное удостоверение на медицинское изделие
Росздравнадзора
|
80 974
80 974 AMD
|
|
|
|||||
|
Для выявления Salmonella spp. из пищи и образцов окружающей среды.
|
|||||||||||
|
HiMedia
|
|||||||||||
|
M1327-500G
|
|
500 г
|
92 807
92 807 AMD
|
|
|
||||||
|
Для первичного и вторичного обогащения, выделения и подсчета Listeria monocytogenes в пищевых продуктах и кормах для животных.
|
|||||||||||
|
M031-500G
|
|
500 г
|
Регистрационное удостоверение на медицинское изделие
Росздравнадзора
|
62 085
62 085 AMD
|
|
|
|||||
|
Для выделения и подсчета Salmonella typhi и других сальмонелл.
|
|||||||||||
|
HiMedia
|
|||||||||||
|
M073-500G
|
|
500 г
|
60 873
60 873 AMD
|
|
|
||||||
|
Для выделения и культивирования (после добавления крови) многих притязательных микроорганизмов, в том числе таких возбудителей инфекций, как стрептококки и нейссерии.
|
|||||||||||
|
HiMedia
|
|||||||||||
|
M096-500G
|
|
500 г
|
64 582
64 582 AMD
|
|
|
||||||
|
Для выделения и подсчета дрожжевых и плесневых грибов в молочных и других пищевых продуктах.
|
|||||||||||
|
HiMedia
|
|||||||||||
|
M618-500G
|
|
500 г
|
Регистрационное удостоверение на медицинское изделие
Росздравнадзора
|
65 792
65 792 AMD
|
|
|
|||||
|
Для накопления вибрионов Vibrio spp.
|
|||||||||||
|
HiMedia
|
|||||||||||
|
M614-500G
|
|
500 г
|
Регистрационное удостоверение на медицинское изделие
Росздравнадзора
|
50 609
50 609 AMD
|
|
|
|||||
|
Служит средой первичного обогащения, которую используют для повышения высеваемости поврежденных сальмонелл из пищевых продуктов (перед селективным обогащением и выделением).
|
|||||||||||
|
HiMedia
|
|||||||||||
|
M383-500G
|
|
500 г
|
Регистрационное удостоверение на медицинское изделие
Росздравнадзора
|
73 561
73 561 AMD
|
|
|
|||||
|
Для выделения клинически значимых культур стафилококков.
|
|||||||||||
|
MH011-500G
|
|
500 г
|
30 294
30 294 AMD
|
|
|
||||||
|
Для тестов на стерильность, а также среду используют в качестве основной для культивирования широкого круга микроорганизмов.
|
|||||||||||
|
HiMedia
|
|||||||||||
|
M011-500G
|
|
500 г
|
Регистрационное удостоверение на медицинское изделие
Росздравнадзора
|
29 866
29 866 AMD
|
|
|
|||||
|
Для тестов на стерильность. Также среду используют в качестве основной для культивирования широкого круга микроорганизмов.
|
|||||||||||
|
HiMedia
|
|||||||||||
|
M244-500G
|
|
500 г
|
Регистрационное удостоверение на медицинское изделие
Росздравнадзора
|
52 248
52 248 AMD
|
|
|
|||||
|
Является питательной средой общего назначения.
|
|||||||||||
|
HiMedia
|
|||||||||||
|
M290-500G
|
|
500 г
|
59 162
59 162 AMD
|
|
|
||||||
|
Для культивирования широкого круга микроорганизмов.
|
|||||||||||
|
M189-500G
|
|
500 г
|
76 127
76 127 AMD
|
|
|
||||||
|
Для селективного выделения и культивирования вибрионов, вызывающих холеру и пищевые отравления.
|
|||||||||||
|
HiMedia
|
|||||||||||
|
M091A-500G
|
|
500 г
|
Регистрационное удостоверение на медицинское изделие
Росздравнадзора
|
72 848
72 848 AMD
|
|
|
|||||
|
Для культивирования не очень прихотливых микроорганизмов или для приготовления специальных сред (после добавления 10% крови или другой биологической жидкости).
|
|||||||||||
|
M154-500G
|
|
500 г
|
Регистрационное удостоверение на медицинское изделие
Росздравнадзора
|
71 922
71 922 AMD
|
|
|
|||||
|
HiMedia
|
|||||||||||
|
M580-500G
|
|
500 г
|
Регистрационное удостоверение на медицинское изделие
Росздравнадзора
|
77 624
77 624 AMD
|
|
|
|||||
|
Стандартная неингибирующая среда для дифференциации и подсчета бактерий в молоке.
|
|||||||||||
|
HiMedia
|
|||||||||||
|
M078-500G
|
|
500 г
|
58 165
58 165 AMD
|
|
|
||||||
|
Для изучения у грамотрицательных бактерий кишечного происхождения способности ферментировать глюкозу и лактозу, а также продуцировать сероводород.
|
|||||||||||
|
HiMedia
|
|||||||||||
|
GM049-500G
|
|
500 г
|
66 932
66 932 AMD
|
|
|
||||||
|
Используется для выделения, обнаружения и подсчета E. aerogenes
бактерии в воде, молоке, других молочных продуктах, а также в клинических образцах. |
|||||||||||
|
M1590-500G
|
|
500 г
|
Регистрационное удостоверение на медицинское изделие
Росздравнадзора
|
78 765
78 765 AMD
|
|
|
|||||
|
Для подсчета дрожжей и плесневых грибов в молоке и молочных продуктах.
|
|||||||||||
|
HiMedia
|
|||||||||||
|
M307-500G
|
|
500 г
|
Регистрационное удостоверение на медицинское изделие
Росздравнадзора
|
77 268
77 268 AMD
|
|
|
|||||
|
Для проверки масла в соответствии с требованиями Международной Молочной Федерации.
|
|||||||||||
|
HiMedia
|
|||||||||||
|
M933-500G
|
|
500 г
|
75 058
75 058 AMD
|
|
|
||||||
|
Для культивирования и подсчета микроорганизмов, вызывающих порчу цитрусовых, культивирования лактобактерий и других кислотолюбивых микроорганизмов, а также патогенных грибов.
|
|||||||||||
|
SD043-5VL
|
|
500 шт/уп
|
транспортировка -20°C
|
16 109
16 109 AMD
|
|
|
|||||
|
Антибиотический препарат группы пенициллинов.
|
|||||||||||
|
SD016-5VL
|
|
500 шт/уп
|
хранение -20°C, транспортировка +2...+8 °C
|
12 759
12 759 AMD
|
|
|
|||||
|
Антибиотики аминогликозидного ряда широкого спектра действия.
|
|||||||||||
|
|
|||||||||||
Вход в личный кабинет
Оформление заказа без регистрации
Для продолжения регистрации введите ИНН
Восстановление пароля
Ссылка для восстановления пароля будет отправлена на Ваш адрес электронной почты
Регистрация пользователя
Заполните, пожалуйста, форму регистрации
Все поля со звездочкой (*) обязательны для заполнения
Все поля со звездочкой (*) обязательны для заполнения
Техподдержка пользователей
Для более быстрого оформления запроса выберите тему обращения
Отмена регистрации
Вы уверены, что хотите отменить создание учетной записи и удалить все данные?
Данное действие необратимо.
Данное действие необратимо.
Да, удалить
Нет, оставить
Зарегистрируйтесь на dia-m.ru,
чтобы сделать работу на сайте еще удобнее!
чтобы сделать работу на сайте еще удобнее!
С помощью личного кабинета Вы сможете:
- моментально получать счета на оформленные заказы;
- отслеживать статусы выполнения заказа по оплате, отгрузке, наличию товаров на складе;
- вести историю заказов, повторять заказы полностью или частично;
- выбирать персонального менеджера;
- формировать списки избранного среди товаров, справочных материалов и видео;
- делать заказ со страницы избранных товаров;
- экономить время при заполнении форм заказа по каталогам и регистрации на мероприятия.

